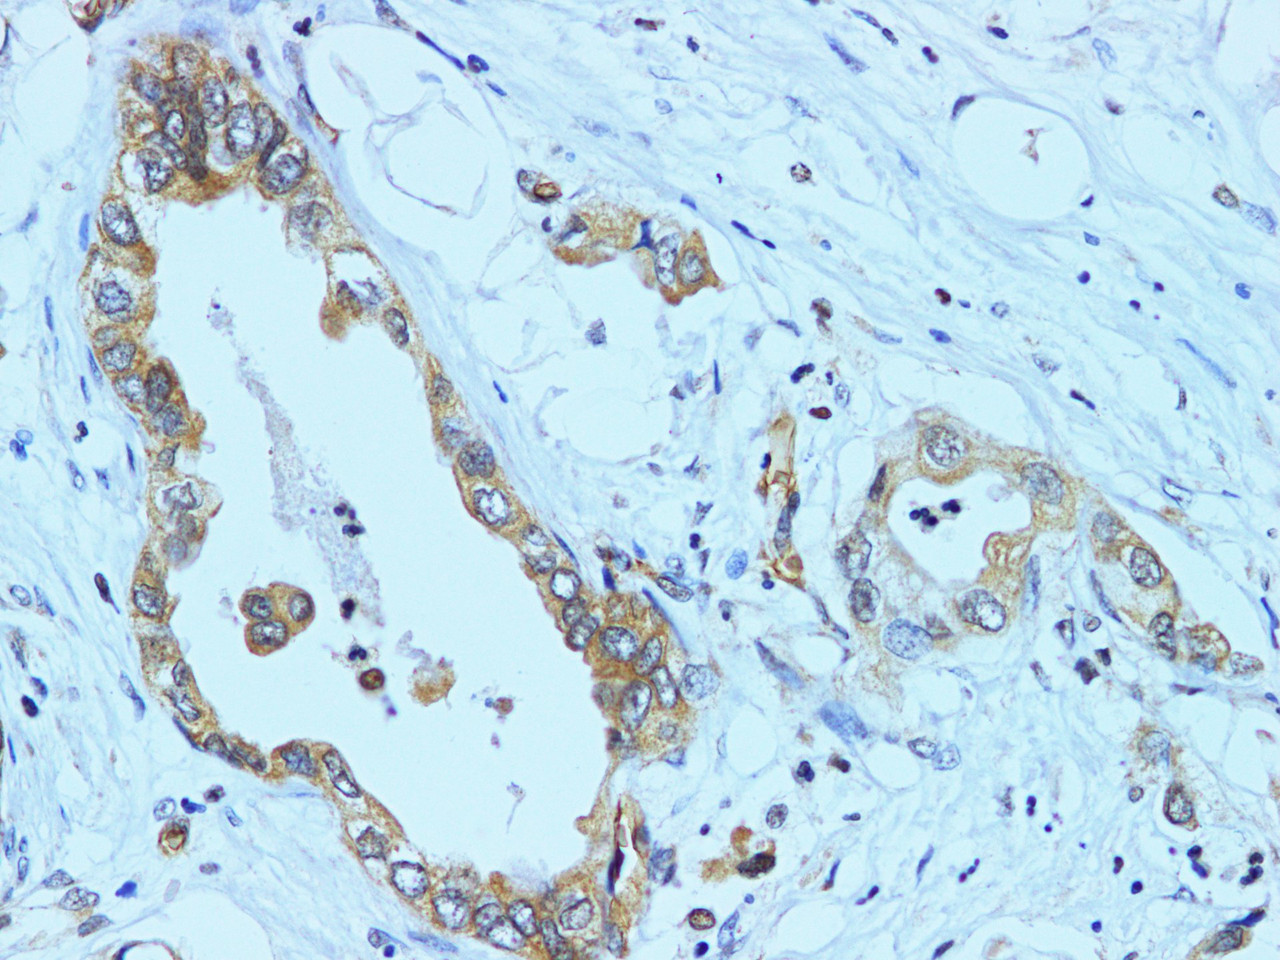
Immunohistochemistry of paraffin-embedded Human pancreatic cancer using NF2 Polyclonal Antibody at dilution of 1:100(400×)

Product Description
NF2 Polyclonal Antibody | E-AB-40336 | Elabscience
Type: Polyclonal Antibody
Synonyms: ACN, BANF, Bilateral acoustic neuroma, MERL, Merlin, Moesin ezrin radixin like protein, Moesin ezrin radizin like, Moesin-ezrin-radixin-like protein, Neurofibromatosis 2, Neurofibromatosis type 2, Neurofibromatosis2, Neurofibromin 2, Neurofibromin-2, Neurofibromin2, NF 2, Nf2, SCH, Schwannomerlin, Schwannomin
Application: IHC
Reactivity: Human
Host: Rabbit
Isotype: IgG
Reserch Areas: Cancer, Epigenetics and Nuclear Signaling, Neuroscience, Signal Transduction
Background: This gene encodes a protein that is similar to some members of the ERM (ezrin, radixin, moesin) family of proteins that are thought to link cytoskeletal components with proteins in the cell membrane. This gene product has been shown to interact with cell-surface proteins, proteins involved in cytoskeletal dynamics and proteins involved in regulating ion transport. This gene is expressed at high levels during embryonic development; in adults, significant expression is found in Schwann cells, meningeal cells, lens and nerve. Mutations in this gene are associated with neurofibromatosis type II which is characterized by nervous system and skin tumors and ocular abnormalities. Two predominant isoforms and a number of minor isoforms are produced by alternatively spliced transcripts.
Concentration: 2 mg/mL
Storage: Store at -20°C. Avoid freeze / thaw cycles.
Immunogen: Recombinant Human Merlin protein
Buffer: PBS with 0.05% Proclin300 and 50% glycerol, pH7.4.
Purification Method: Affinity purification
Dilution: IHC 1:100-1:200
Clone: N/A
Conjugation: Unconjugated
Molecular Weight(Calculated): N/A
Molecular Weight(Observed): N/A
 Euro
Euro
 USD
USD
 British Pound
British Pound
 NULL
NULL